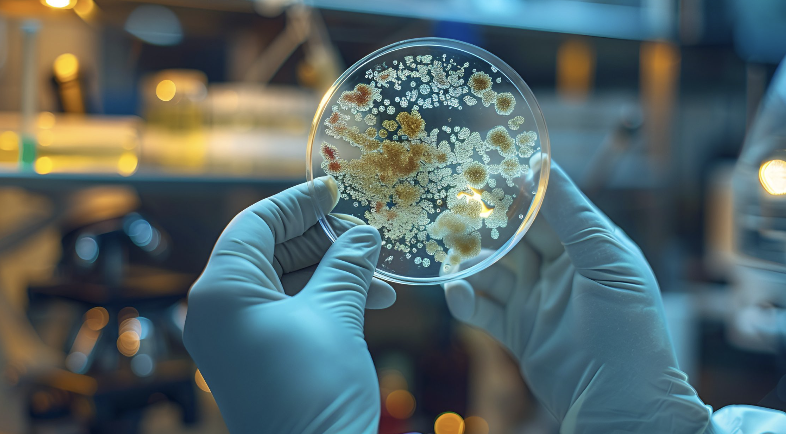
LABORATORY

UV-DISINFECTION
자외선 살균은 단파장 UVC 방사선을 사용하여 공기, 표면 또는 액체를 처리하는 것을 설명합니다. 세포를 손상시키는 효과 덕분에, 이는 기존 소독 방법에 대한 효과적이고 화학물질이 없는 대안이 됩니다.
UV-C 기술은 박테리아, 바이러스, 효모, 그리고 곰팡이와 같은 미생물을 비활성화하며, 따라서 신뢰할 수 있는 세균 감소가 요구되는 광범위한 응용 분야에서 관련이 있습니다.
예를 들어, 식품 산업의 회사들은 오염을 최소화하고 제품의 저장 수명을 연장하기 위해 UV 시스템을 사용합니다. 그 밖에도, UV 처리는 많은 분야에서 핵심적인 역할을 하는데, 이는 화학물질의 필요성을 크게 줄이거나 심지어 완전히 대체할 수 있기 때문입니다. 이는 물 처리뿐만 아니라 공기 소독과 표면 위생에도 적용됩니다.
따라서 UV 구성 요소와 시스템은 효율적인 세균 감소를 가능하게 하며, 심지어 무균 환경을 만들 수도 있습니다.
당사의 UV 솔루션
UV-C 방사선이란?

UV-C 방사선은 자연 햇빛의 일부이며 미생물에 대항하는 강력한 도구입니다. UV-C는 박테리아, 바이러스, 곰팡이의 DNA 또는 RNA를 교란하여 증식하지 못하게 하는 방식으로 물리적으로 작동합니다.
왜 중요할까요?
- 화학물질 없이, 잔류물 없이 – 제품과 환경에 안전합니다
- 효과적이고 신뢰할 수 있음 – 공정을 오염으로부터 보호합니다
- 다양한 적용 – 공기, 표면, 물, 악취 저감에 적용할 수 있습니다
UV-C 소독은 어떻게 작동하는가?
UV-C는 운영 전반에 걸쳐 빠르고 안전하며 지속 가능한 보호를 제공합니다:
- 미생물 사멸 – 박테리아, 바이러스, 곰팡이의 확산을 차단합니다
- 화학물질 또는 잔류물 없음 – 순수한 물리적 과정입니다
- 검증되고 신뢰할 수 있음 – 식품, 물, 공기, 실험실 분야에서 전 세계적으로 사용됩니다
적절한 UV-C 기술을 선택하세요
Hoenle은 필요에 맞추어 전체 UV 스펙트럼에 걸친 솔루션을 제공합니다:
- 저압(LP) – 제어된 적용을 위해 254 nm에서 정밀하고 효율적인 살균 효과를 제공합니다
- 중압(MP) – 대용량을 빠르게 처리하기 위한 고강도 광대역 UV를 제공합니다
- 펄스 광(PL) – 빠른 표면 및 소재 소독을 위한 짧고 고에너지의 펄스를 제공합니다
고객님의 이점: 적용 분야에 최적인 기술을, 검증된 방식으로 안전하게 적용하실 수 있습니다.
실질적인 이점을 제공하는 적용 분야
- 공기 소독 – 공기 중 병원체를 줄이고 실내 공기질을 개선합니다
- 표면 소독 – 위생적이고 안전한 표면을 유지합니다
- 수처리(정수) – 운영 또는 생산을 위한 병원체 없는 물을 보장합니다
- 악취 제거 – 박테리아 또는 소재로 인해 발생하는 냄새를 효율적으로 제거합니다
- 실내 공기 건조 – 민감한 환경에서 위생과 운영 효율을 지원합니다
- 부품 및 맞춤형 솔루션 – 공정에 원활하게 통합되는 고품질 UV 모듈을 제공합니다
- 실험실 서비스 – 신뢰할 수 있는 결과를 보장하기 위한 전문 시험, 검증 및 공정 최적화를 제공합니다
고객 혜택: 최대 위생, 안전한 제품, 운영 효율, 그리고 안심입니다.